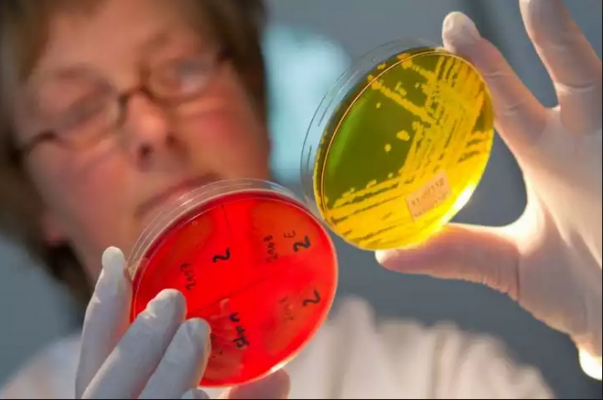

Qoʻshimcha funksionallar
-
Tungi ko‘rinish
Jahon yangiliklari
Jahon yangiliklari

08:29 / 15.05.2015
AQSh Fors ko‘rfazidagi ittifoqchilarini himoya qilishga tayyor
08:25 / 15.05.2015
Rossiyada ichak kasalliklari bo‘yicha ish qo‘zg‘atildi

08:20 / 15.05.2015
Falastinda qochqinlarni xotirlash kuni o‘tkazilmoqda

07:24 / 15.05.2015
Fors ko‘rfazi davlatlari AQShning NATOdan tashqaridagi asosiy ittifoqchilariga aylanishi mumkin

07:06 / 15.05.2015
Nepal bosh vaziri hukumat ikkinchi zilzilaga tayyor bo‘lmaganini tan oldi

06:34 / 15.05.2015
Ukraina Rossiya bilan chegarasini mustahkamlaydi

06:30 / 15.05.2015
2016 yilda Obama yana arab yetakchilari bilan uchrashadi

19:42 / 14.05.2015
Yaman o‘zining Erondagi elchisini chaqirtirib olmoqda

19:33 / 14.05.2015
Yelena Isinbayevaga mayor harbiy unvoni berildi

19:11 / 14.05.2015
Ramzon Qodirov 17 yoshli kelinni Galkinga qiyosladi

18:25 / 14.05.2015
Yevroosiyo iqtisodiy ittifoqi Eron bilan birga erkin savdo hududini yaratishni rejalashtirmoqda

18:23 / 14.05.2015
Poroshenko nemislarga Rossiya gazetalarini o‘qimaslikni maslahat berdi

18:14 / 14.05.2015
Avstraliya Papua-Yangi Gvineyadan mustaqil bo‘lishga intilayotgan orolda elchixona ochdi

18:11 / 14.05.2015
Turkiya NATOning IShIDga qarshi kurashda aniq strategiyasi yo‘qligini aytdi

17:41 / 14.05.2015



